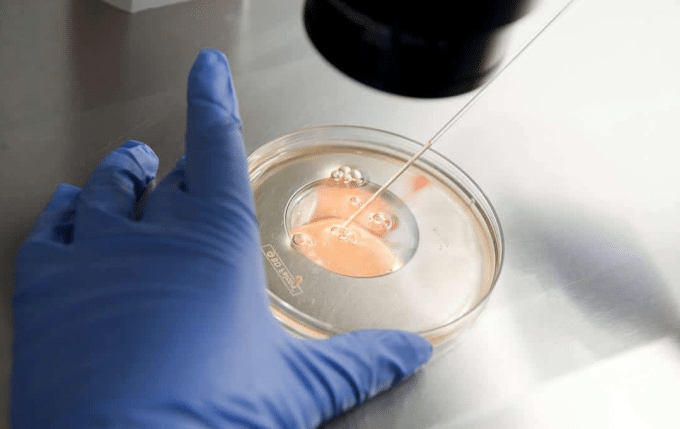

Polycystic Ovary Syndrome (PCOS) is a hormonal imbalance, in which a woman’s ovaries produce androgens or male hormones in excess, affecting her ovulation. The condition can cause all sorts of problems in women who have it, from changes in the menstrual cycle to infertility.
According to information from the Mexican Social Security Institute (IMSS), around 6% of Mexican women of reproductive age are living with polycystic ovary disease and manifest different problems related to this condition, ranging from irregular menstrual periods to infertility.
What are the symptoms of polycystic ovary and when to see a doctor?
The symptoms of polycystic ovary can manifest themselves through:
- Menstrual disturbances such as amenorrhoea.
- Unwanted hair growth (hirsutism) on the face, chest, lower abdomen, legs or buttocks.
- Acne or skin blemishes.
- Alopecia.
- Muscle hypertrophy and breast atrophy.
- Weight gain and obesity.
If you have one or more of these symptoms, have questions about your menstrual periods, or have signs of excess male hormones, it is important to see a gynecologist who can do a full evaluation and determine if you have PCOS.
How is Polycystic Ovary Syndrome diagnosed?
For properly diagnose a woman with polycystic ovarian disease requires a physician to perform hormonal hormonal studies, may also use a transvaginal transvaginal ultrasound to look at the number of follicles, which is usually between 6 and 12 for each ovary.
In women with this condition, more than 30 to 40 follicles may be observed, which often compromises the ovulation process, causing problems in achieving a successful pregnancy.
What treatment is available for Polycystic Ovary Syndrome?
Each case is different, so it is essential that you consult a specialist to help you determine the best treatment for you.
However, to treat these conditions, doctors often combine treatment with a low-calorie diet and moderate physical activity.
To regulate your menstrual cycle, your doctor might recommend birth control pills (which can also be used to reduce excessive hair growth) or progesterone therapy. Contraceptives decrease androgen production, while progesterone helps regulate menstrual periods.
Pregnancy with polycystic ovary, is it possible?

Infertility is one of the most common problems associated with women with PCOS; this is because the hormonal imbalance does not allow normal ovulation, and it is impossible to conceive when the ovaries do not release an egg; about 40% of women with polycystic ovary disease may experience anovulation, according to IMSS data.
However, nowadays there are different alternatives in Assisted Reproduction to help women with polycystic ovaries to consolidate their desire to become mothers.
Ovulation induction and IVF, the options to have a baby if you have PCOS
The ovulation induction is an Assisted Reproduction treatment, in which drugs such as clomiphene citrate are used to stimulate egg production.
This treatment is particularly recommended for women who:
- They are under 32 years old and their fallopian tubes are patent.
- Have tried unsuccessfully to have a baby for less than 3 years
If medication is not enough to help you conceive, the best option if you have Polycystic Ovary Syndrome is In Vitro Fertilization (IVF). IVF allows you to select the best quality eggs for subsequent fertilization and implantation in your uterus.
If you want to have a baby and you have polycystic ovary syndrome or suspect that you have it, it is important that you go directly to a doctor specialized in reproductive biology, who in addition to being a gynecologist, has specific knowledge and experience in all the Assisted Reproduction alternatives that exist to achieve your dream.
PCOS and the infertility associated with it is no longer an impediment to motherhood!

